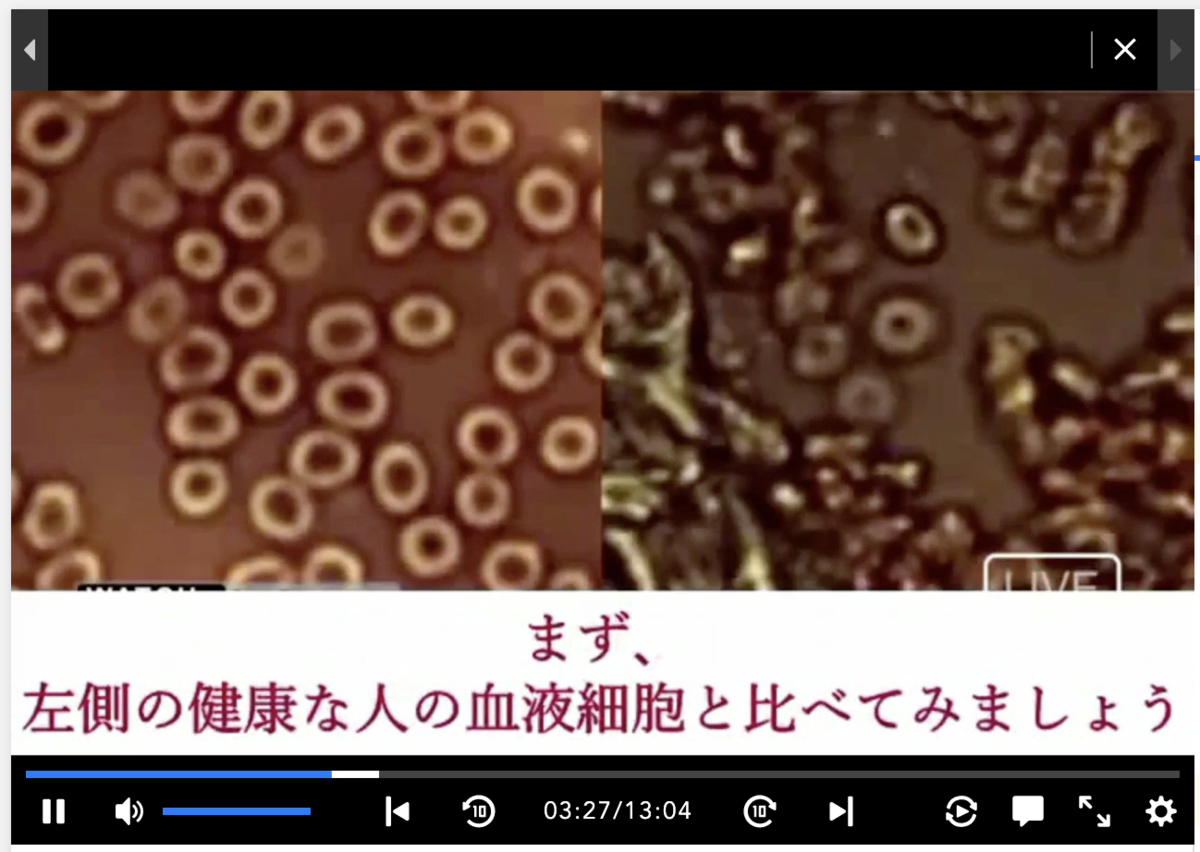
f:id:min117:20210912070436p:plain

ワクチンは「重症化を抑える」ためのもの。「他人に感染させない(拡大を抑える)」という効果はない。
ワクチンはあくまで
自分のため(重症化を抑える)ためであって、
他人のため(感染させない)ためのものではない。
だから、打つか打たないかは自分を基準に考えて良い。考えるべき。
他人にうつすかもしれないからワクチンを打とうという考えだけは絶対にしてはいけない。
ワクチン打ってたって他人には感染する(+させられる)んだから。
※「ワクチンパスポートを持っていたら外出OK」というのも論理的に間違っている。ワクチン打ってたって他人には感染する(+させられる)んだから。外出していい理由にはならない。
で、そんなワクチンは打つべきか?
俺は打たない。絶対嫌だね。
本来するべき地道な対策(検査→隔離→補償)を一切講じず、そのための体制を構築しないまま、エイヤ!っとワクチンで何とかしようとするその単純な考え方がまず信用できない。
地道な対応(検査→隔離→補償の繰り返し)をおろそかにして、その体制も作らず、場当たり的な対策しかしてこなかった政府が、その思考で押し進めるワクチン接種なんて、信用のしようがない。
もしこれが、仮に検査体制が全国に構築できていて
「陽性率が7%を超えている地域では、リスクより効果(再生産を抑える)が高いので摂取してください」
(地域ごとに対策が打てる/それだけのデータと積み重ねがある)
とか
「検査の結果、高齢ハイリスクグループ、高齢低リスクグループ、中年…若年…グループと分けられて、そのうち最初のグループには再生産のリスクが客観的に明らかになったので、そこだけは摂取してください」
(グループごとに対策が打てる/そういう区分けができてる)
のように、検査に基づいた、根拠ある摂取推奨であれば、喜んで打っていただろう。
今のまま、ワクチンだのみではこのパンデミックは絶対に収まらない。場当たり的にワクチンを打ってみても、次から次へと変異するだけでキリがない。
ワクチン?いつ打ったっけ?デルタに打ったやつだっけ?ガンマ?ミュー株?あれ、俺いま何回打ったっけか?
となるのは目に見えている。
そうやって、拙速に、まともな治験もないワクチンを何回も(体内に直接)摂取した結果が安全である保証はどこにもない。
仮にワクチンが原因で死亡したとしても、「因果関係は不明」として処理されてしまう。
実際そうなった。


これはつまり
「死んでも自己責任だよ」
「ワクチン打ったお前が自分で判断したんでしょ」
「あんたが悪い」
ということだ。政治はそういう姿勢だということ。ワクチンで死んでも無駄死にである。
だからこそ、打つかどうかは慎重に、自分が、自分だけが判断する。していい。他人のためとか、うつさないためとか綺麗ゴトは考えちゃダメ。死んでも誰も責任とってくれない。
実際のところワクチンの安全性はどうなのか。
これも、別に専門家じゃなくても、判断の材料は十分ある。
・ワクチンは通常、十分な治験期間を減て世に出てくるはず。
→ ごく短期間で出てきた。コロナそのものが世に現れてから2年足らずなのに。もうワクチンがある時点でおかしい。十分な治験期間を経ていないことは物理的にわかる。

「いやそれでもリスクよりは効果のほうが大きいと思うから、自分は打つよ」という人は打てばいい。俺は絶対打たない。
・他の病気や薬との関係性が示されていない
→ 例えばガンの人、透析の人…世の中にはたくさんの病気があり、他の薬を飲んでる人もいるわけだが、それらの人がワクチン打って大丈夫という保証はどこにもない(今まさに全国で人体実験中だ)。
高血圧の薬を飲む人はグレープフルーツを摂ってはいけない。血栓をできにくくする薬を飲む人は納豆を摂取してはよくない。これらはよく知られてると思うが、その人がワクチン打ったらどうなるのか。なぜ「ワクチンを打っても(皆が)安全」と言えるのか。
こんな報道もある。
これを真に受けすぎるのもどうか(だいぶ誇張がある)とは思うが、体内に直接入れたワクチンが血液に影響することは本当だろう。実際に実害が出てる(血栓ができる、発熱する、モデルナアームになる)ことを見ても、全く影響がないと考えるほうがどうかしている。
実際のところ、日常のニュース報道ではワクチンを打ったあとの顕微鏡映像は一切報道されていない。打ったあとの腫れた腕すら映像には載らないのだから、その隠蔽度合いが、かえってこういう報道の信憑性を強くする。
・2回、3回と重ねて打つことの安全性は保証されていない
→ むしろ「5回目から死亡する例が激増」という情報はある。

・異物混入
→ 「視界が砂嵐で見えない」「音が遠くに鳴る」という実害が出ているのに「因果関係は不明」と言われてしまっている。

これで「打っても安全だ」と考えるほうがどうかしている。
以上、今ある情報を自分の頭で考えて、自分の身体のこととして判断した結果、俺は絶対に打たない。
しかしこの「打って当たり前」のような、この国の空気。報道。ほんと狂ってるね。狂想状態だ。そのうち「ワクチン打ったやつだけが謎の死」「厚労省、因果関係は不明と発表」となっても、何の不思議もない。
日本の薬害の歴史

子宮頸がんワクチン被害が抜けてるな


副反応が出ても、たらい回し。まともじゃない。








救済制度も使えない。副反応なのに、自腹で医療費を払い続けなきゃならない。

こんなもの、打つほうがどうかしてる。






